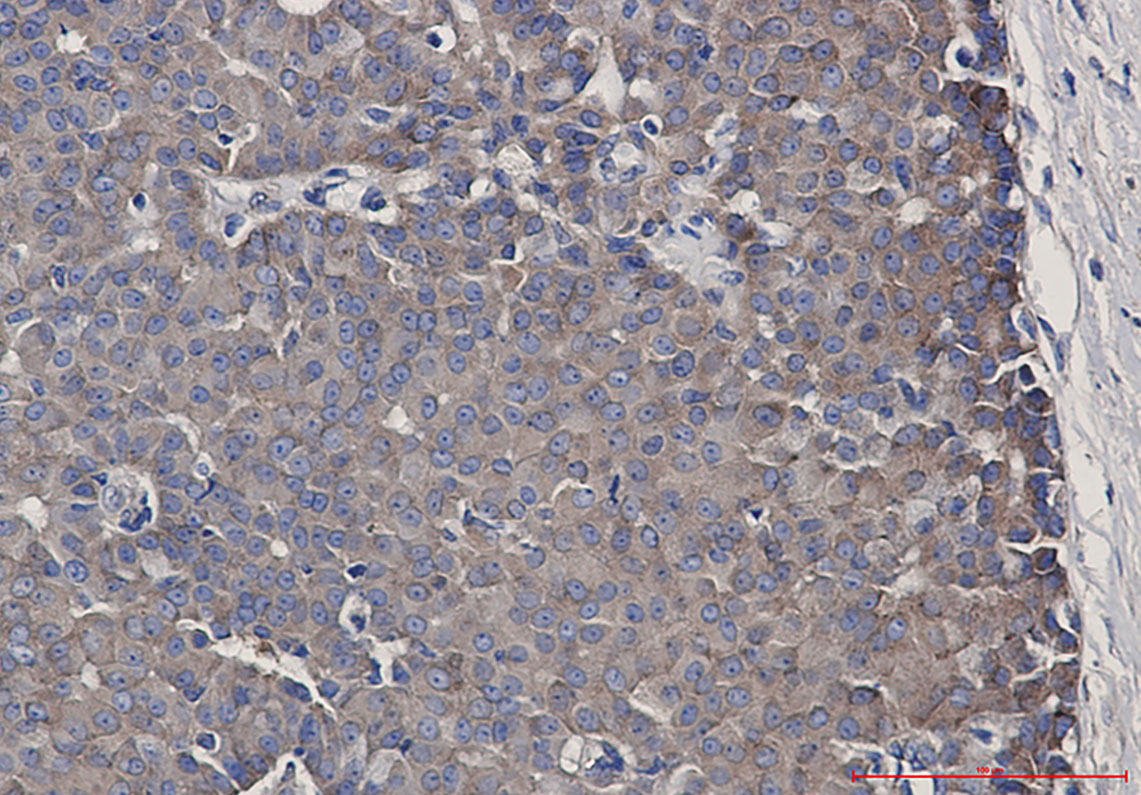

-
分类: 科研抗体货号: P22271别名: ALL; CML; PHL; BCR1; D22S11; D22S662应用: WB,IP,IHC反应种属: Human,Rat
-
分类: 科研抗体货号: P22261别名: activating transcription factor 3应用: WB,IP反应种属: Human
-
分类: 科研抗体货号: P22270别名: BCL10; CIPER; CLAP; B-cell lymphoma/leukemia 10; B-cell CLL/lymphoma 10; Bcl-10; CARD-containing molecule enhancing NF-kappa-B; CARD-like apoptotic protein; hCLAP; CED-3/ICH-1 prodomain homologous E10-like regulator; CIPER; Cellular homolog应用: WB,IP反应种属: Human
-
分类: 科研抗体货号: P22260别名: AT3; JOS; MJD; ATX3; MJD1; SCA3应用: WB反应种属: Human
-
分类: 科研抗体货号: P22268别名: BCLG应用: WB,IP,IF反应种属: Human,Mouse,Rat
-
分类: 科研抗体货号: P22287别名: MCH3; CMH-1; LICE2; CASP-7; ICE-LAP3应用: WB,IHC反应种属: Human,Mouse,Rat
-
分类: 科研抗体货号: P22267别名: BDK; BCKDKD应用: WB反应种属: Human,Mouse,Rat
-
分类: 科研抗体货号: P22285别名: CSNK2B; CK2N; G5A; Casein kinase II subunit beta; CK II beta; Phosvitin; Protein G5a应用: WB,IHC,IF反应种属: Human,Mouse,Rat
-
分类: 科研抗体货号: P22266别名: Homeobox protein BarH-like 1应用: WB,IP反应种属: Human,Rat,Hamster
-
分类: 科研抗体货号: P22284别名: CARS1; CYSRS; MGC:11246应用: WB,IHC反应种属: Human,Rat

鄂公网安备42018502007531号
鄂公网安备42018502007531号

